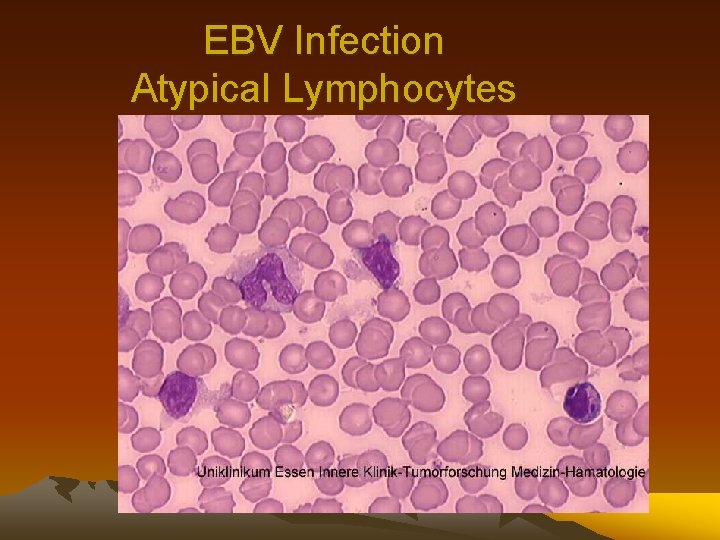
EBV Infection Atypical Lymphocytes

Common viral infections HERPES VIRUS INFECTIONS The objectives

Common viral infections HERPES VIRUS INFECTIONS • The objectives of this lecture: Ø To know the clinically important HVs. Ø To know the common characteristics of HVs. Ø To know the common modes of transmission of different HVs Ø To know the clinical features of these infections, diagnostic methods and treatment.

HERPES VIRUSES • • Herpes Simplex Virus type 1 (HSV-1) Herpes Simplex Virus type 2 (HSV-2) Varicella Zoster Virus (VZV) Cytomegalovirus (CMV) Epstein-Barr Virus (EBV) Human Herpes Virus 6 (HHS-6) Human Herpes Virus 7 (HHS-7) Human Herpes Virus 8 (HHS-8)

HERPES VIRUSES Characteristics: • • • They are all DNA viruses All are encapsulated All have latency after the initial infection Mostly require close contact for transmission Human is the only reservoir

Virus Infection HSV Type 1 Herpes labialis ('cold sores') Keratoconjunctivitis Finger infections ('whitlows') Encephalitis Primary stomatitis Genital infections HSV Type 2 Genital infections Neonatal infection (acquired during vaginal delivery) Varicella zoster virus (VZV) Chickenpox Shingles (herpes zoster) Cytomegalovirus (CMV) Congenital infection Disease in immunocompromised patients Pneumonitis Retinitis Enteritis Generalised infection Epstein-Barr virus (EBV) Infectious mononucleosis Burkitt's lymphoma Nasopharyngeal carcinoma Oral hairy leucoplakia (AIDS patients) Human herpes virus 6 (HHV-6) and 7 (HHV-7) Exanthem subitum ? Disease in immunocompromised patients Human herpes virus 8 (HHV-8) Associated with Kaposi's sarcoma

HERPES VIRUSES Structure

HERPES VIRUSES

HERPES VIRUSES • HSV-1 vs HSV-2 Non-genital vs Genital Herpes infection Primary vs Recurrent infections Neonatal infection

HERPES VIRUSES • Transmission by close contact with body secretions • Exposure to HSV at mucosal surfaces or abraded skin sites permits entry of the virus and initiation of its replication in cells of the epidermis and dermis • After initial infection the virus infect the sensory and autonomic nerves and become dormant in the ganglion (trigeminal nerve for HSV 1 and sacral rout for HSV 2)

HSV Gingivostomatitis and pharyngitis are the most frequent clinical manifestations of first-episode HSV-1 infection

Herpes Labialis Recurrent herpes labialis is the most frequent clinical manifestation of reactivation HSV infection

NON-GENITAL HSV

GENITAL HSV Fever, headache, malaise, and myalgias. Pain, itching, dysuria, vaginal and urethral discharge, and tender inguinal lymphadenopathy

Genital HSV Herpetic ulceration of the vulva Penile herpes simplex (HSV-2) infection

GENITAL HSV

Diagnosis of HSV • • Clinical picture Viral culture Cytology PCR

HSV TREATMENT • • aciclovir 200 mg five times daily. famciclovir 250 mg 8 -hourly. valaciclovir 500 mg 12 -hourly. The treatment is usually for 5 days

VARICILLA ZOSTER VIRUS • Primary infection Chickenpox • Recurrent infection Herpes zoster

VARICILLA ZOSTER VIRUS The virus is spread by the respiratory route and replicates in the nasopharynx or upper respiratory tract. Followed by localized replication at an undefined site, which leads to seeding of the reticuloendothelial system and, ultimately, viremia. The virus establishes latency within the dorsal root ganglia.

CHICKENPOX Overall, chickenpox is a disease of childhood, because 90% of cases occur in children younger than 13 years of age.

VARICILLA ZOSTER Reactivation of VZV leads to VZ

VARICILLA ZOTER

VARICILLA ZOSTER

VARICILLA ZOTER

VARICILLA ZOTER

VZV Diagnosis • Clinical picture • Viral culture

VZV treatment • Acyclovir • Valacyclovir • Famciclovir Prevention VZV vaccination VZV immunoglobulin (VZIG)

Cytomegalovirus (CMV) • • The largest virus that infect human being World wide distribution Latency after primary infection Infection ranges from asymptomatic to sever multisystem disease

CMV Seroepidemiology

Cytomegalovirus (CMV) Primary infection Asymptomatic Infectious mononucleosis Secondary infections in Immunocompromised patients: Pneomonitis Retinitis GI Multisystem

CMV Retinitis

Cytomegalovirus (CMV) Diagnosis almost always depends on laboratory confirmation and cannot be made on clinical grounds alone. ♦Viral cultures from blood , urine , tissue. ♦Serologic tests (antigen detection) ♦ PCR

Cytomegalovirus (CMV) TREATMENT ganciclovir foscarnet cidofovir

Epstein-Barr Virus (EBV) • Ubiquitous human herpes virus. • By adulthood 90 to 95% of most populations are positive. • Spread occurs by intimate contact between susceptible individuals and asymptomatic shedders of EBV. • Mostly causes asymptomatic infections. • Strong association with African Burkitt's lymphoma and Nasopharyngeal carcinoma.

Epstein-Barr Virus (EBV) Infectious mononucleosis Clinical Fever, Sore throat , Lymphadenopathy Hematologic >50% mononuclear cells >10% atypical lymphocytes Serologic Transient appearance of heterophile antibodies Permanent emergence of antibodies to EBV

Epstein-Barr Virus (EBV) Diagnosis: Heterophile Antibodies is present in about 90% Hematologic Findings Lymphocytosis, neutropenia , throbocytopenia EBV specific antibodies
EBV Infection Atypical Lymphocytes

EBV Infection Atypical Lymphocytes

EBV Infection

Epstein-Barr Virus (EBV) Treatment: Treatment of infectious mononucleosis is largely supportive because more than 95% of the patients recover uneventfully without specific therapy Corticosteroids

• Suggested readings; • Davidson’s Principles and Practice of Medicine 20 th edition • Kumar & Clark's clinical medicine 7 th edition
- Slides: 40